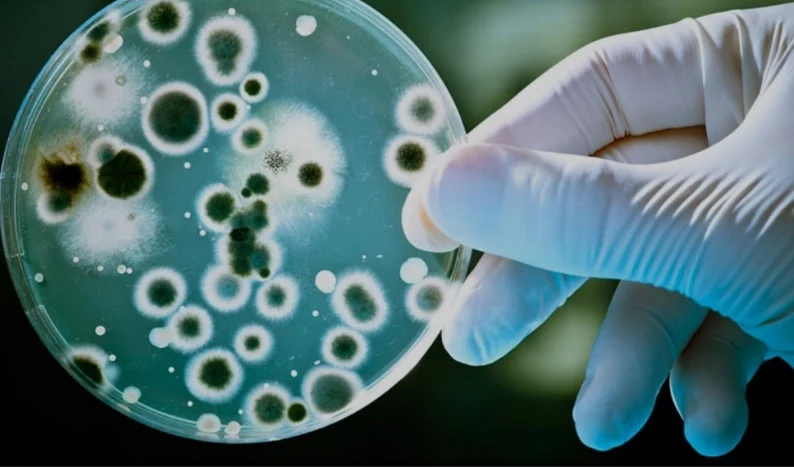

Сарып – адамдар мен мал арасында кездесетін жұқпалы ауру. Бұл ауруға барлық үй жануарлары шалдығады. Көп жағдайда адамдардың сарыпты жұқтыруына қой мен ешкі себеп болады.
Ауру мал іш тастағанда бөлінетін сұйық заттарымен, өлі түскен төлмен бірге аурудың қоздырғыштары сыртқы ортаға тарап, жайылым, қора, құрал-сайман, шөп, су ластануы мүмкін. Сарып ауруы ауру малдың ет-сүт өнімдерін шикі немесе термиялық өңдеуден өткізбей пайдаланғанда, сонымен қатар резеңке қолғапты пайдаланбай ауру малды сою, қырқу және терісін өңдеу кезінде жұғады. Қызылорда облысының санитариялық-эпидемиологиялық бақылау департаменті ауру малды төлдету, қойдың жүнін қырқып, одан өнім алу кезінде арнайы жұмыс киімін, резеңке қолғапты пайдалану қажеттігін, сүт және сүт өнімдерін, ет және ет өнімдерін қолданар алдында термиялық өңдеуден міндетті түрде өткізу қажеттігін еске салады.
Аурудың клиникалық белгілері – дене қызуының көтерілуі, тершеңдік, дене салмағын жоғалту. Індетке шалдыққан адамның буындары ауырып, бұлшық еттері мен жүйке жүйесі зақымданады. Жыныс мүшелеріне әсер еткен жағдайда ерлерде орхитке, әйелдерде түсік тастауға, жатырдың қабынуына, мастит ауруларына әкеліп соқтырады. Ал балалар мен жасөспірімдерді белсіздік ауруымен зақымдауы мүмкін. Дер кезінде дәрігерге қаралмаған жағдайда ауру асқынып, мүгедектікке әкеліп соқтыруы ықтимал.
2025 жылы облыста алғаш анықталған бруцеллез ауруының 19 жағдайы есепке алынды. Аурушаңдық көрсеткіші 2024 жылмен салыстырғанда 1 жағдайға төмендеген, жасөспірімдер арасында 4 жағдайға азайған.
Сақтық шараларын орындаған жағдайда аурудың алдын алуға болатындығын естен шығармаңыз.
Г. Сыздыкова
Қызылорда облысының СЭБД басшысы
Жылдам ақпарат алу үшін Facebook, Instagram желілері мен Telegram каналымызға жазылыңыз!